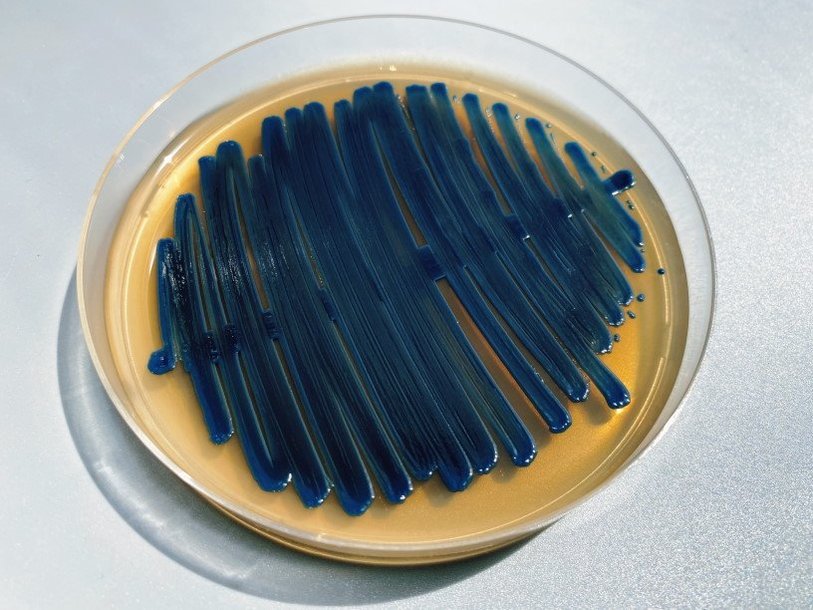

Екатерина Беленко: Промикробы: Вооружен и очень опасен
Фото: Екатерина Беленко
Фото: Екатерина Беленко Продолжим знакомство с крошечными представителями фауны, способными подпортить работу пищеварительной системы. Про лямблий и энтамёб вы уже почти всё знаете, сегодня — прошу любить и жаловать — криптоспоридии.
⠀
Криптоспоридии — род паразитических протистов из типа апикомплекс. Апикомплексы (они же в народе споровики) — это такой тип простейших. Да, название странное, но очень логичное. Ведь всех представителей этого типа объединяет наличие на определенной стадии развития особого специфического комплекса органелл — апикального комплекса. Слово «апикальный» всего лишь указывает на расположение на вершине или кончике чего-либо, достаточно универсальное слово в биологии. Для чего же малышам этот особый комплекс? Для проникновения! Апикальный комплекс имеется у подвижных стадий, а состоит он из кучи страшных и непонятных слов — из трехмембранной пелликулы, субпелликулярных микротрубочек, микропоры, полярных колец, роптрий, микронем и коноида.
⠀
Коноид — это усеченный конус из микротрубочек, расширяющийся вглубь, участвующий в процессе проникновения через покровы инфицируемой клетки. Роптриями называют органеллы, заполненные содержимым, растворяющим покровы клетки и тем облегчающим проникновение внутрь. Роль микронем, предположительно, заключается в синтезе веществ, дополняющих секрет роптрий. Одним словом, эти ребята вооружены и подготовлены к тому, чтобы проникнуть в наши клетки. Неудивительно, что ещё одним представителем этого типа является малярийный плазмодий, но о нём в другой раз.
⠀
Представители рода Сryptosporidium — паразиты млекопитающих, птиц, рептилий и рыб. Как и у других споровиков, покровы криптоспоридий представлены пелликулой, однако характерные для апикомплекс микропоры в покровах не обнаружены. Коноид в составе апикального комплекса выражен слабо. Расшифровка генома Cryptosporidium parvum продемонстрировала крайнюю степень специализации криптоспоридий к паразитизму. Было обнаружено чрезвычайное упрощение метаболических путей и зависимость от питательных веществ хозяина. Значительно редуцированными оказались и митохондрии, предположительно, тоже утратившие собственный геном.
⠀
Не все, но некоторые виды криптоспоридий способны поражать человека, вызывая заболевание пищеварительной системы криптоспоридиоз, обычно не опасное для людей со здоровой иммунной системой, однако часто являющееся фатальным для людей, страдающих иммунодефицитом. Криптоспоридиоз, как правило, проявляется как острая и кратковременная инфекция и распространяется алиментарным путём, часто через заражённую воду. Основным симптомом у людей с неповреждённой иммунной системой является диарея, больные, страдающие иммунодефицитом, испытывают гораздо более серьёзные симптомы, часто со смертельным исходом.
⠀
Заражение начинается с попаданием вместе с водой или пищей в пищеварительный тракт хозяина покоящейся стадии паразита — ооцисты. Дальнейший жизненный цикл криптоспоридий многоэтапный и запутанный, я и так вас напугала коноидом и роптриями, поэтому опустим детали. Маленький паразит внедряется в клетку, размножается и, пройдя несколько различных стадий, на выходе из человека — снова ооцисты. Круг замкнулся. Симптомы обычно появляются примерно на 7-й день после заражения. Заболевание часто вызывает острую или хроническую диарею, которая может длиться в течение нескольких недель. Помимо диареи, пациенты могут страдать от боли в области желудка, судорог и слабой лихорадки. В случае, когда паразиты распространяются за пределы кишечника, как это часто происходит у больных СПИДом, они могут достигать лёгких, среднего уха, поджелудочной железы и желудка. Паразит может поражать желчевыводящие пути, что приводит к холециститу. Короче, мыть руки стоит не только из-за коронавируса.
Смотрите также: Екатерина Беленко Промикробы: Инфекция наносит ответный удар Екатерина Беленко Промикробы: Ода кишечной микрофлоре Екатерина Беленко Среда для микробиологов Екатерина Беленко Микробы, они везде